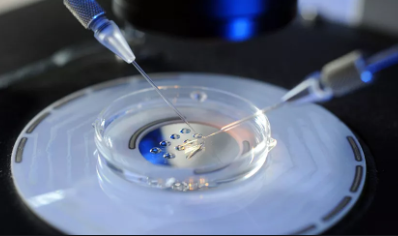

智特医疗张欣博士谈美国试管婴儿:冻卵的成功率有多少? 圆梦美好??
2021-07-29 12:33:04,浏览量: 1083次
没有女性不怕变老,但是随着年龄的增长,生育能力也渐渐衰退。这时,会后悔为什么没有早点要孩子。但是,现在有一项技术可以使您保持生育能力,即冷冻卵子。
国内已有不少女明星(徐静蕾,林志玲等人)表示已经冻卵,为未来生育先买份“保险”,但是冻卵的成功率会如我们所愿吗?
冻卵是将卵子转移至零下196°C的液氮罐中进行储存,需要时将其取出并解冻。但是卵子冷冻的成功率有多高呢?很多人只认为冷冻卵子可以防止卵子随着年龄的增长而老化,但他们没有考虑复苏后卵子的质量。
一方面冷冻卵子并没有100%的复苏率,目前,卵子的回收率仅为70%至80%。卵子对温度和保护剂更敏感。不仅可能在冷冻过程中受损,而且在解冻过程中也可能受损。解冻的过程中可能破坏卵子的细胞结构。
另一方面智特医疗辅助生殖专家张欣博士谈到了一个更现实的问题。冻卵过程中我们能知道你取了多少个卵,其中有多少成熟的卵,而且成熟的卵自然会全部进行冷冻,
但这个并不代表一个成功率。
张欣博士给大家分析一个现状:成功率是你未来卵解冻以后有多少卵能恢复?复活的卵里有多少能跟精子结合形成胚胎?这样的胚胎有多少能形成受精卵?受精卵里面能有多少正常的受精卵?这些正常的受精卵里移植以后,成功孕育又成功活产的几率是多少?事实上我们要的是最终的结果和最后的答案。
在冻卵时大家更多的去问的一个问题,是冻了多少个卵?
从科学上讲目前来讲,所有的临床数据显示:希望大家能冻到15-20个卵。
如果冻到15-20个卵,你未来能得到一个孩子的几率,目前看是大于70%。
当然我们又看到冻卵者的年龄,因为卵子质量和年龄密切相关。不同的年龄的女性得到卵的数量可能相同,但质量绝不相同。
30岁的女性得到20个卵,跟40岁的女性得到20个卵,结果自然是差别很大,而且卵子质量可能是天壤之别。所以我们劝大家如果想冻卵,应该第一时间去完成。在你年轻的时候冻卵。珍惜冻卵的最佳年龄,35岁之前。有人追问 30岁之前冻卵早不早?不早,而且一定要趁早。
对于大龄女性,智特医疗团队会根据每个人不同的状况来去给大家去推荐:是不是还能冻卵?你是不是需要考虑冷冻胚胎?会量身定制最适合的方案。
在整个这个过程之中,对于客人自身能把握的就是:第一时间去完成这项任务。冻卵本身具有其不确定性,因为你今天即使得到了十个新鲜的卵,但是自己都不知道它会产生一个什么结果?我们选择冻卵,就是把这个结果的探索过程放到3年、5年、 10年以后,再去回答这个答案,短期是得不到答复的。
怎么才能获得答复呢?应该去把自己的卵跟精子结合起来。有的时候我们经常推荐大龄女性冻卵同时冻胚胎。今天冻的胚胎会把你未来冷冻的卵解冻以后的结果提前告诉你。这应当是最理想的答案。